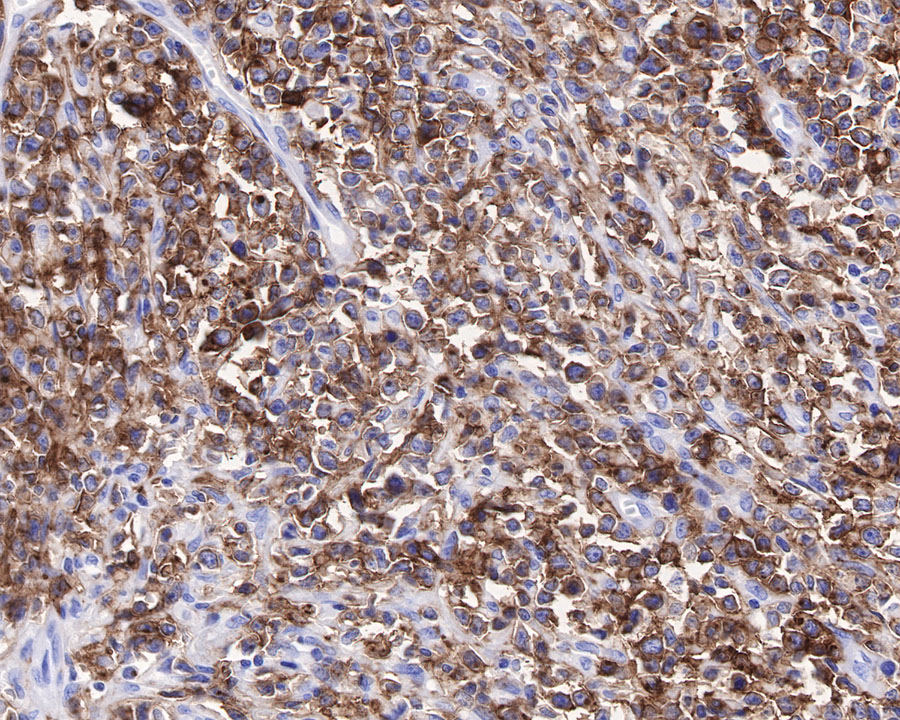
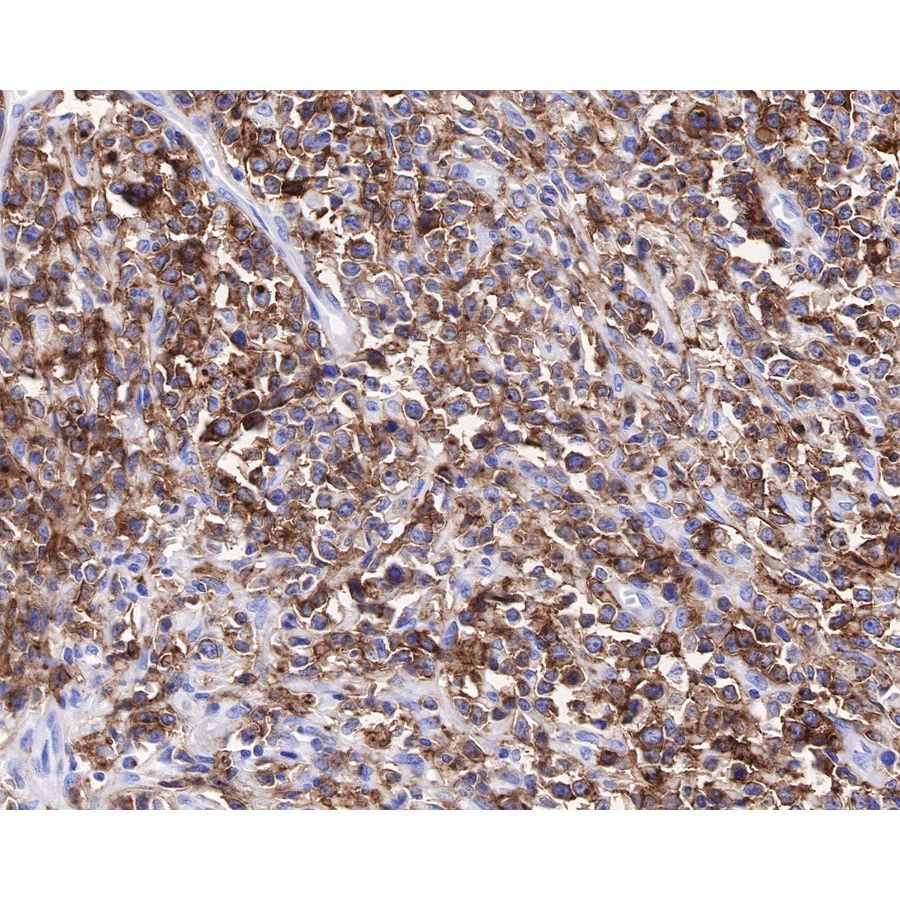
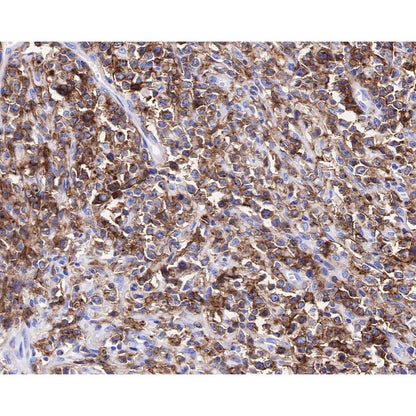

Product Specification
| Host |
Rabbit |
| Antigen |
CXCR5 |
| Synonyms |
C-X-C chemokine receptor type 5, BLR1, MDR15, CD185 |
| Immunogen |
Synthetic Peptide |
| Location |
Cell membrane |
| Accession |
P32302 |
| Clone Number |
SDT-351-24 |
| Antibody Type |
Recombinant mAb |
| Application |
IHC-P, ICC, FCM |
| Reactivity |
Hu |
| Purification |
Protein A |
| Concentration |
0.5 mg/ml |
| Tag |
N/A |
| Physical Appearance |
Liquid |
| Storage Buffer |
PBS, 40% Glycerol, 0.05% BSA, 0.03% Proclin 300 |
| Stability & Storage |
12 months from date of receipt / reconstitution, -20 °C as supplied |
Dilution
| application |
dilution |
species |
| IHC-P |
1:5000 |
|
| ICC |
1:100 |
|
| FCM |
1:500 |
|
Background
CXCR5 is the receptor for the chemokine CXCL13, the chemokine important for secondary lymphoid tissue orchestration and lymphoid neogenesis. CXCL13 is constitutively expressed in secondary lymphoid tissue primarily by follicular dendritic cells in the spleen, lymph nodes, tonsils, and Peyer's patches, whereas CXCR5 is highly expressed in mature B lymphocytes and a subpopulation of follicular B helper T cells (Tfh). CXCL13 and its receptor CXCR5 are essential for trafficking B cells and homing B cells to lymphoid tissues and for the embryonic development of the majority of lymph nodes and Peyer's patches.